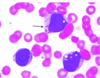

K2 - E19 fuldt eksamenssæt Flashcards
(88 cards)
Hvorfor er det farligt (og kontraindiceret) at give SagM erytrocytkoncentrat af blodtype B RhD negativ til en mandlig patient med blodtype A RhD positiv?
a. Fordi patienten har anti-B antistoffer i sit plasma
b. Fordi patienten har anti-RhD antistoffer i sit plasma
c. Fordi blodportionen indeholder anti-A antistoffer
d. Fordi patienten har anti-A antistoffer i sit plasma
e. Fordi blodportionen indeholder anti-B antistoffer
a. Fordi patienten har anti-B antistoffer i sit plasma
Hvilket fænomen er en vigtig del af patomekanismen ved kronisk organafstødelse (rejektion)?
a. Embolisering af arterierne
b. Apoptose af endothelcellerne
c. Intimafortykkelsen i arteriolerne
d. Hypertrofi af det ramte organ
e. Uratkrystalaflejring i bindevævet
c. Intimafortykkelsen i arteriolerne
55-årig mand kommer til almen praksis. Symptomatologien er hovedpine samt generaliseret kløe specialet ved varme. Blodprøver afslører en på hæmoglobin 12,9 mmol/L, leukocytter 18,3 Mia/L og thrombocytter 960 Mia/L, CRP<5,0.
Hvilken diagnose er mest sandsynlig?
a. Essentiel thrombocytose
b. Akut leukæmi
c. Reaktive blodprøver pga. infektion
d. CML
e. Polycytemia vera
e. Polycytemia vera
Hvilket af følgende udsagn findes altid ved CML
a. JAK-2 positiv og supprimeret s-EPO
b. Cytogenetisk forandring med t(9;22)
c. CALR positiv
d. Forhøjet bilirubin
e. Cytogenetisk forandring med t(15;17)
b. Cytogenetisk forandring med t(9;22)
65-årig mand kommer til egen læge, der tager blodprøver. Blodprøverne viser hæmoglobin 5,0 mmol/l, leukocytter 120 mia/l, thrombocytter 25 mia/l samt MCV 106 fl, CRP 175 mg/l. Hvilken plan vil være den korrekte?
a. Kontrol blodprøver dagen efter
b. Opstarte peroral antibiotika og se patienten om 1 uge
c. Indlægge patienten akut
d. Henvise til ambulant røntgenbillede
e. Afvente urindyrkning inden antibiotika opstart
c. Indlægge patienten akut
En ny diagnosticeret akut myeloid leukæmi patient skal gennemgå intensiv kemoterapi med forventet neutropeniperiode på 3-4 uger. Hvilken type systemisk infektion er den mest sandsynligeved første feberepisode:
a. Urinvejs bakterieflora
b. Svamp
c. Rhinofarynx bakterieflora
d. Opportunistisk bakterieflora
e. Normal tarmflora
e. Normal tarmflora
Hvilket af følgende udsagn er korrekt ved sekundære donor udvælgelseskriterier ved allogen stamcelletransplantation:
a. ABO-forlig, alder, CMV-status, EBV-status, graviditet
b. ABO-forlig, alder, CMV-status, EBV-status, køn
c. ABO-forlig, CMV-status, EBV-status, graviditet, køn
d. Alder, CMV-status, EBV-status, graviditet, køn
e. ABO-forlig, alder, CMV-status, graviditet, køn
e. ABO-forlig, alder, CMV-status, graviditet, køn
Hvilke 3 organer er involveret ved akut graft-versus-host sygdom?
a. Lever, hud og nyre
b. Gastrointestinal-kanal, hud og nyre
c. Lever, gastrointestinal-kanal og nyre
d. Lever, hud, og gastrointestinal-kanal
e. Slimhinderne i øjne, mund og genitalia
d. Lever, hud, og gastrointestinal-kanal
Hvad er sandt vedrørende klassisk cytotoksisk kemoterapi?
a. Neutropeni er en hyppig bivirkning
b. Gives typisk som monoterapi
c. Rammer hovedsageligt celler i G0 (hvile fase)
d. Cisplatin er en proteinkinasehæmmer
e. Kombinationsbehandling eliminerer resistensproblematikken
a. Neutropeni er en hyppig bivirkning
Hvad er sandt vedrørende Antimetabolitter?
a. Danner covalente bindinger til DNA
b. Methotrexat er en folinsyre antimetabolit
c. Leukovorin (folininsyre) er generel antidot til antimetabolitter
d. Ondansetron (5-HT3 receptor blokker) er en purinanalog
e. Antimetabolitters effekt er cyklus-specik
b. Methotrexat er en folinsyre antimetabolit
Hvilket af nedenstående er IKKE et symptom på anæmi?
a. Hoste
b. Åndenød
c. Hovedpine
d. Hjertebanken
e. Iskæmisymptomer som f.eks. angina pectoris
a. Hoste
Hvilken af nedenstående er IKKE en almindelig årsag til jernmangelanæmi?
a. Gastro-intestinal blødning
b. Cøliaki
c. Vegetarisk/vegansk kost
d. Hereditær sfærocytose
e. Kraftige menstruationsblødninger
d. Hereditær sfærocytose
Hvilket af nedenstående udsagn om primær immuntrombocytopeni (ITP) er KORREKT?
a. Cerebrale symptomer er almindelige
b. Er en hæmatologisk cancer der kræver højdosis kemoterapi
c. Patienterne er oftest upåvirkede med isoleret øget blødningstendens
d. Ses især ved fejlernærede
e. Behandling med kortikosteroider som f.eks. prednisolon er kontraindiceret
c. Patienterne er oftest upåvirkede med isoleret øget blødningstendens
Hvilket af nedenstående udsagn om trombotisk trombocytopenisk purpura (TTP) er KORREKT?
a. Cerebrale symptomer er almindelige
b. Er en hæmatologisk cancer der kræver højdosis kemoterapi
c. Patienterne er oftest upåvirkede med isoleret øget blødningstendens
d. Ses især ved fejlernærede
e. Behandling med kortikosteroider som f.eks. prednisolon er kontraindiceret
a. Cerebrale symptomer er almindelige
Om von Willebrand sygdom gælder:
a. At diagnosen stilles ved måling af von Willebrand faktor koncentration og funktion sammenholdt med en relevant blødningsanamnese
b. At sygdommen skyldes medfødt mangel på koagulationsfaktor VIII
c. At sygdommen er forbundet med øget trombosetendens
d. At sygdommen er sjælden i Danmark med en prævalens på ca. 0,1%
e. At sygdommen primært rammer mænd, sfa. X-bunden arvegang
a. At diagnosen stilles ved måling af von Willebrand faktor koncentration og funktion sammenholdt med en relevant blødningsanamnese
Hvad er korrektvedrørende hæmostasen og vurderingen heraf med almindelige blodprøver?
a. Den sekundære hæmostase består i særdeleshed af von Willebrand faktor, der adhærerer til karskaden, undergår konformationsændring og binder trombocytterne
b. APTT står for Aktiveret partiel thromboplastin tid og er en screeningstest for den sekundære hæmostases interne pathway og er et funktionelt udtryk for mængden af koagulationsfaktorer
c. INR er et funktionelt udtryk for mængden af koagulationsfaktorerne II, VIII og X, udregnet som internationalt normaliseret resultat
d. APTT er en meget standardiseret analyse, således vil prøver målt på forskellige laboratorier med forskellige reagenstyper alligevel give meget enslydende resultater
e. Der udredes typisk for antithrombin mangel, Protein D mangel og Protein S mangel ved en trombofiliudredning. Disse er almindelige koagulationshæmmere, hvorfor mangel medfører øget tromboserisiko
b. APTT står for Aktiveret partiel thromboplastin tid og er en screeningstest for den sekundære hæmostases interne pathway og er et funktionelt udtryk for mængden af koagulationsfaktorer
En 49-årig aymptomatisk kvinde har tilfældigt opdaget en uøm hævet lymfeknude på ca. 3 cm. Foran m. Sternocleidomatoideus på højre side. PET/CT scanning af hals, thorax og abdomen viser patologisk FDG optagende universel lymfadenopati med største lymfommål på 3 x 4 cm i retroperitoneum. LDH er 260 IU/l. Hb 8,1 mmol, trombocytter 354 mia/l, leukocytter 9.2 mia/l.
Hvilken diagnose er mest sandsynlig ?
a. Follikulært lymfom
b. Mb Hodgkin
c. Diffust storcellet B-lymfom
d. Kronisk lymfatisk lekæmi
e. Burkit lymfom
a. Follikulært lymfom
Hvilket udsagn om klassisk Hodgkin lymfom stadie 2A er korrekt?
a. Kan ses an med ”wait and watch” strategi
b. Skal behandles højdosis kemoterapi og autolog stamcelletransplantation i 1. linje
c. Har en god prognose ved behandling med kombination af kemoterapi og stråleterapi i 1. linje
d. Er forbundet med moderat risiko for tumorlysesyndrom efter iværksat behandling
e. Skal behandles med kemoterapi med særlig god CNS penetrans for at undgå senere CNS recidiv
c. Har en god prognose ved behandling med kombination af kemoterapi og stråleterapi i 1. linje
En 70-årig mand som for 15 måneder siden blev behandlet til komplet remmission for et diffust storcellet B-celle lymfom stadie 4B, bliver indlagt i den fælles akutmodtagelse med et generaliseret tonisk-klonisk krampetilfælde. Der er tale om et førstegangs tilfælde. Han er afebril. Biokemisk ses normal hæmoglobin, trombocytter og leukocytter. Kreatinin 120 mikromol/l, Natrium 140 mmol/l, Kalium 4,8 mmol/l, Ca-ion 1,25mmol/l. LDH 550 U/l. Hvad skal primært mistænkes?
a. Bakteriel menigitis
b. Apopleksia cerebri
c. Relaps af lymfom i CNS
d. Spontan tumorlyse pga relaps
e. Sekundær cancer pga tidligere kemoterapi
c. Relaps af lymfom i CNS
En 40-årig kvinde klager over træthed og kvalme gennem 3 måneder. Ved objektiv undersøgelse ses talrige pustler i ansigtet, samt splenomegali og hepatomegali. Laboratorieundersøgelser viser Hb på 4,0 mmol/l og trombocytter på 50 mia/l. Ovenstående billede viser blodudstrygning. Patienten udvikler diffus purpura, gingivalblødning og laboratorietal tydende på dissemineret intravaskulær koagulation. Hvilken af følgende diagnoser er den mest sandsynlige?
a. Akut lymfoblastær leukæmi
b. Akut megakaryocyt leukæmi
c. Akut promyelocyt leukæmi
d. Kronisk myeloid leukæmi
e. Akut monocyt leukæmi
c. Akut promyelocyt leukæmi
Knoglemarvsceller fra en organdonor dyrkes in vitro ved 37°C i medie med rekombinant erytropoietin. Billedet viser typiske kolonier. Denne kolonidannelse repræsenterer hvilken af følgende fysiologiske adaptationer til transmembranøs signalering?
a. Atrofi
b. Dysplasi
c. Hyperplasi
d. Hypertrofi
e. Metaplasi

c. Hyperplasi
Cytogenetisk undersøgelse af follikulært lymfom fra en 40-årig mand demonstrerer en t(14;18) kromosomal translokation involverende BCL2-genet. Konstitutiv ekspression af proteinet kodet af dette gen inhiberer hvilken af følgende processer i patientens transformerede lymfocytter?
a. Apoptose
b. DNA excision repair
c. G1-til-S cellecyklus progression
d. Oxidativ fosforylering
e. Protein (N-linked) glykosylering
a. Apoptose
Cytogenetiske studier af blod fra en 70-årig kvinde med kronisk myeloid leukæmi viser en t(9;22) kromosomal translokation. Hvilket af følgende forklarer bedst hvilken rolle denne translokation spiller i patogenesen af denne patients leukæmi?
a. Ændret DNA metyleringsstatus
b. Øget ekspression af telomerase
c. Ekspansion af trinucleotid repeat
d. Inaktivering af tumor suppressor protein
e. Protoonkogen aktivering

e. Protoonkogen aktivering
En 66-årig kvinde har arbejdet hele sit liv på en lille familiegård nær Tokyo. Ingen tidligere væsentlige sygdomme. Har følt sig tiltagende træt og svag gennem det seneste år. Ved obj. undersøgelse er hun afebril men bleg. Laboratorieundersøgelser viser Hb 7,0 mmol/l, Hct 33,8%, trombocytter 205 x 109/l, og leukocytter 64 x 109/l. Immunfænotypering giver ovenfor viste fund. Hvis det antages at den dominerende cellepopulation er klonal, hvilken af følgende vira er mest sandsynligt involveret i denne patients sygdomsproces?
a. Human papilloma virus
b. HIV-1
c. Epstein-Barr virus
d. Human T-celle lymfotrop virus type 1
e. Hepatitis B virus
d. Human T-celle lymfotrop virus type 1







